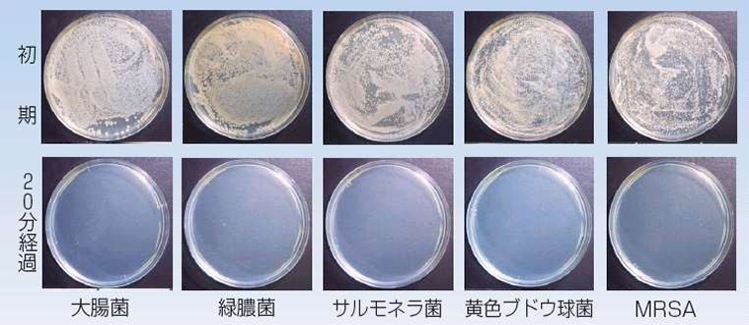

付着菌に対しての
試験データ
2インチ四方の24ゲージ、2Bステンレス鋼を安定化二酸化塩素と微生物の媒体として使用し、安定化二酸化塩素(pH3.5~4.5に調整)を用いて暴露試験を行い、次のような結果が得られています。
鋼板に微生物を接種し、各濃度の安定化二酸化塩素を噴霧し、所定の暴露時間ごとに50mlの中和液中で15秒間試験鋼板を攪拌し、液中の希釈物をペトリ皿に付着させ培養液を流し込み、35°C、48時間培養しました。
好気性菌は肉汁中で培養し、嫌気性菌はペプドンコロイド状培基を用いました。
【2.5分後に菌が死滅した濃度(単位:ppm)】

■試験機関:(社)京都微生物研究所(厚生労働省指定検査機関/厚生労働省第650号)
■試験目的:殺菌力評価試験 ■試験方法:殺菌法

6畳2ヶ月持続

1回1~2プッシュ


単品購入よりお得!
買い切り複数購入パック

浄化空間 置き型タイプ
3個セット単発
6畳2ヶ月持続
送料
無料
7,440円(税込)
/1個あたり2,480円
※北海道、沖縄、その他離島を除く

浄化空間 置き型タイプ
5個セット単発
6畳2ヶ月持続
送料
無料
10,900円(税込)
/1個あたり2,180円
※北海道、沖縄、その他離島を除く
![]()
サブスク(定期購入)パック
![]()

浄化空間 置き型タイプ
1個定期(2ヶ月毎)
6畳2ヶ月持続
送料
無料
2,480円(税込)
/1個あたり2,480円
※北海道、沖縄、その他離島を除く
![]()

浄化空間 置き型タイプ
3個定期(2ヶ月毎)
6畳2ヶ月持続
送料
無料
6,540円(税込)
/1個あたり2,180円
※北海道、沖縄、その他離島を除く
![]()

浄化空間 置き型タイプ
5個定期(2ヶ月毎)
6畳2ヶ月持続
送料
無料
9,900円(税込)
/1個あたり1,980円
※北海道、沖縄、その他離島を除く
おためし
単品購入はこちら
使用上の注意
キャップを開けてパッキンを取り、キャップのみをボトルに装填して使用して下さい。
製品は傾けて保管したり、破損・転倒・転落などしないようにして下さい。
直射日光・高温・多湿を避けて保管・使用して下さい。
安定した所に設置して下さい。
火気を近づけないで下さい。また、ご使用後火中に投じないで下さい。
ご使用後は各自治体の方法・規則に従って廃棄して下さい。
応急処置
誤食した場合は直ちに吐き出させて下さい。
使用中に気分が悪くなった場合は直ちに使用を中止し、速やかに換気をして通気の良いところで安静にして下さい。
皮膚に付いたり眼に入った場合は直ちに水で洗い流して下さい。
いずれの場合においても異常がある場合は医師にご相談下さい。